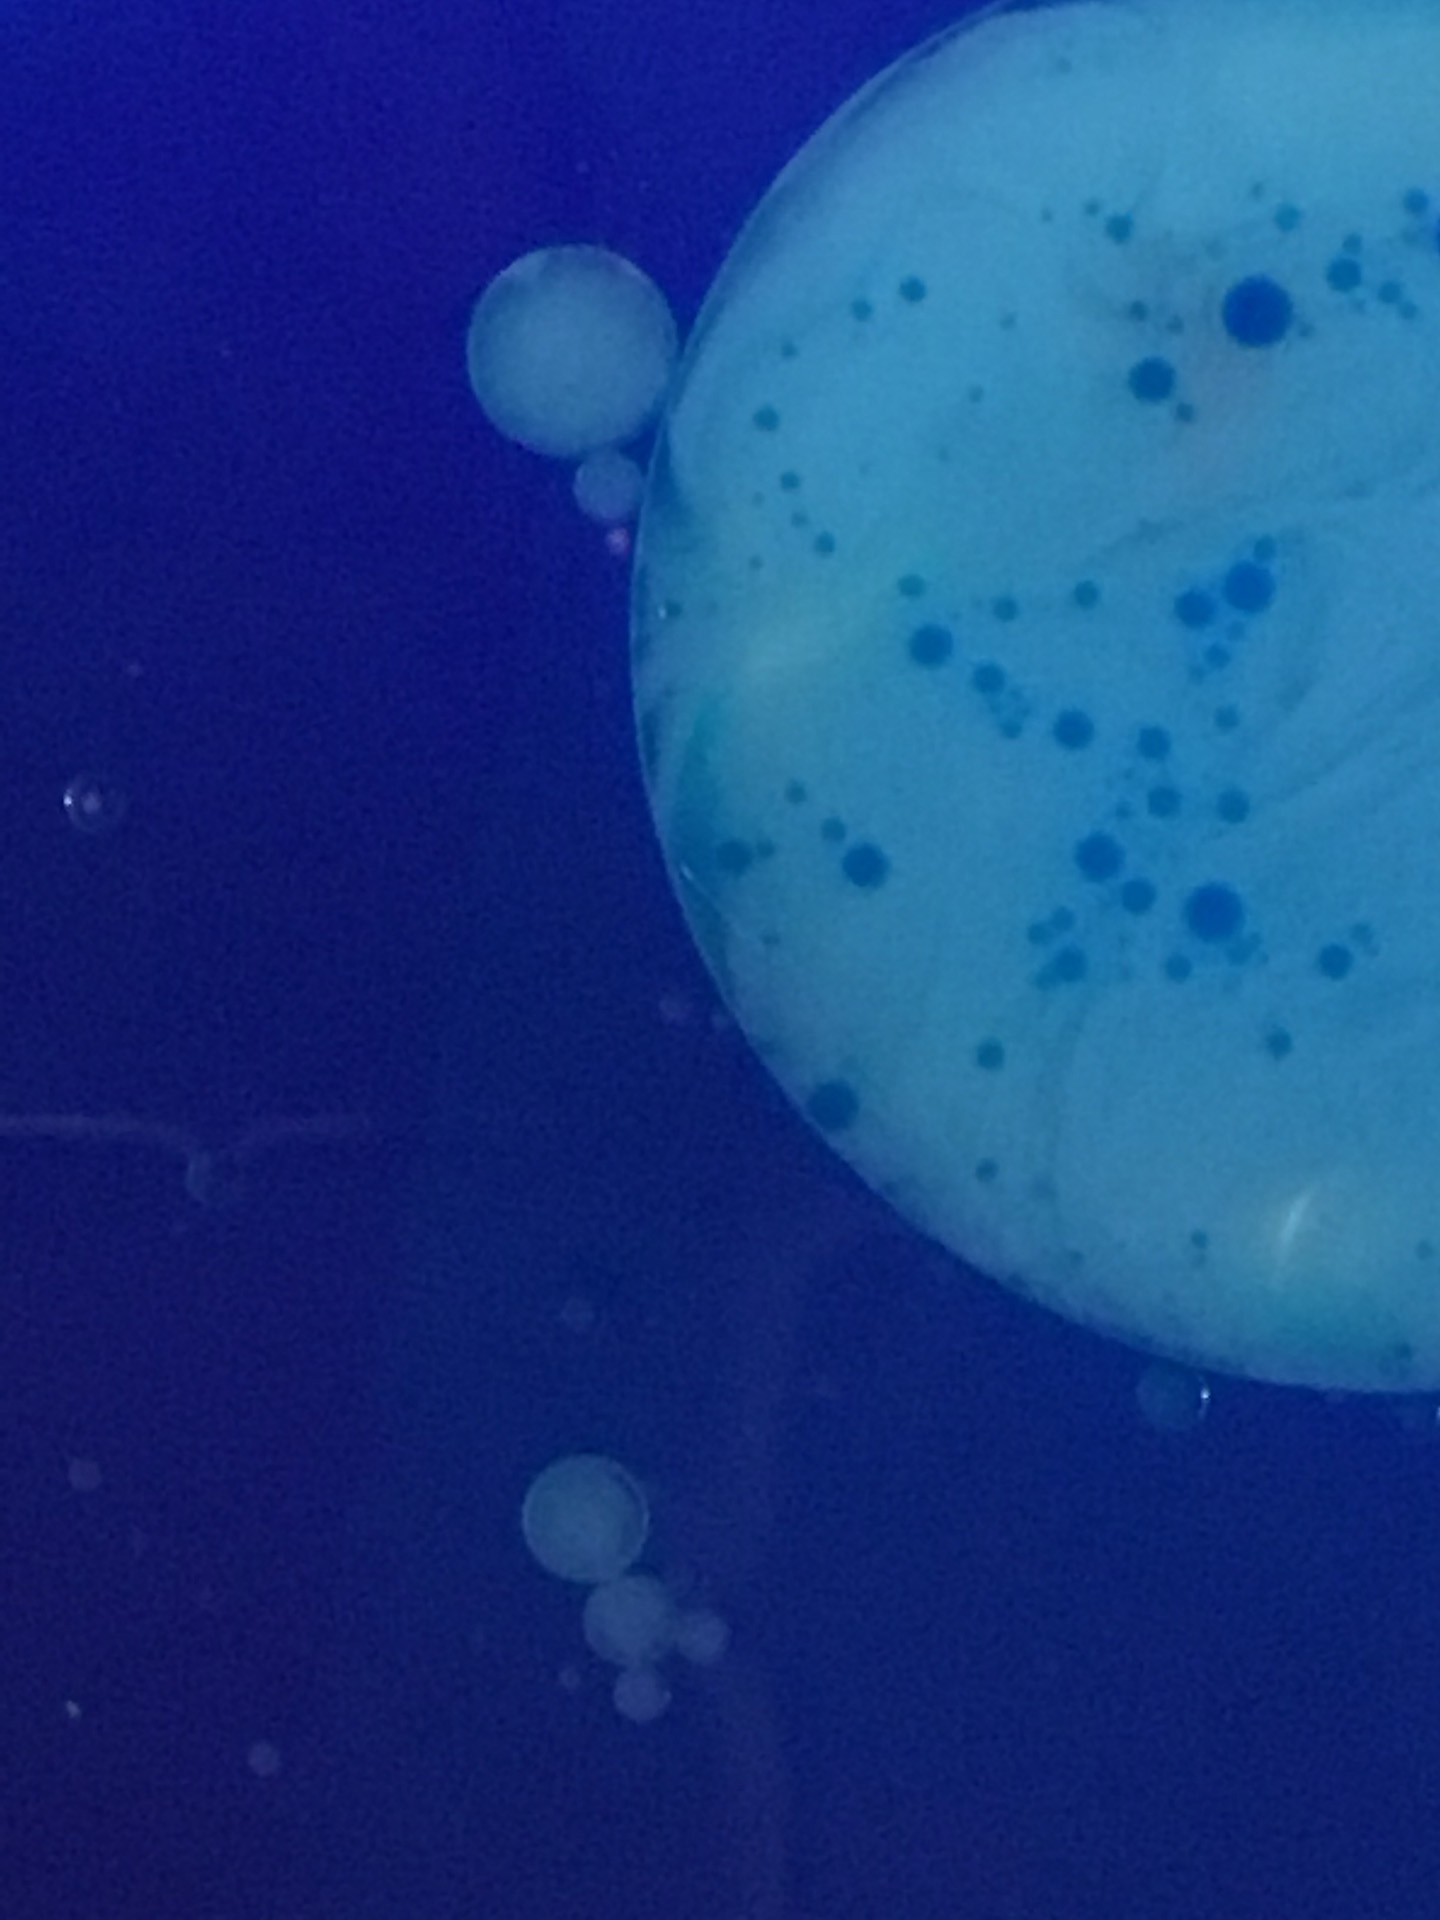
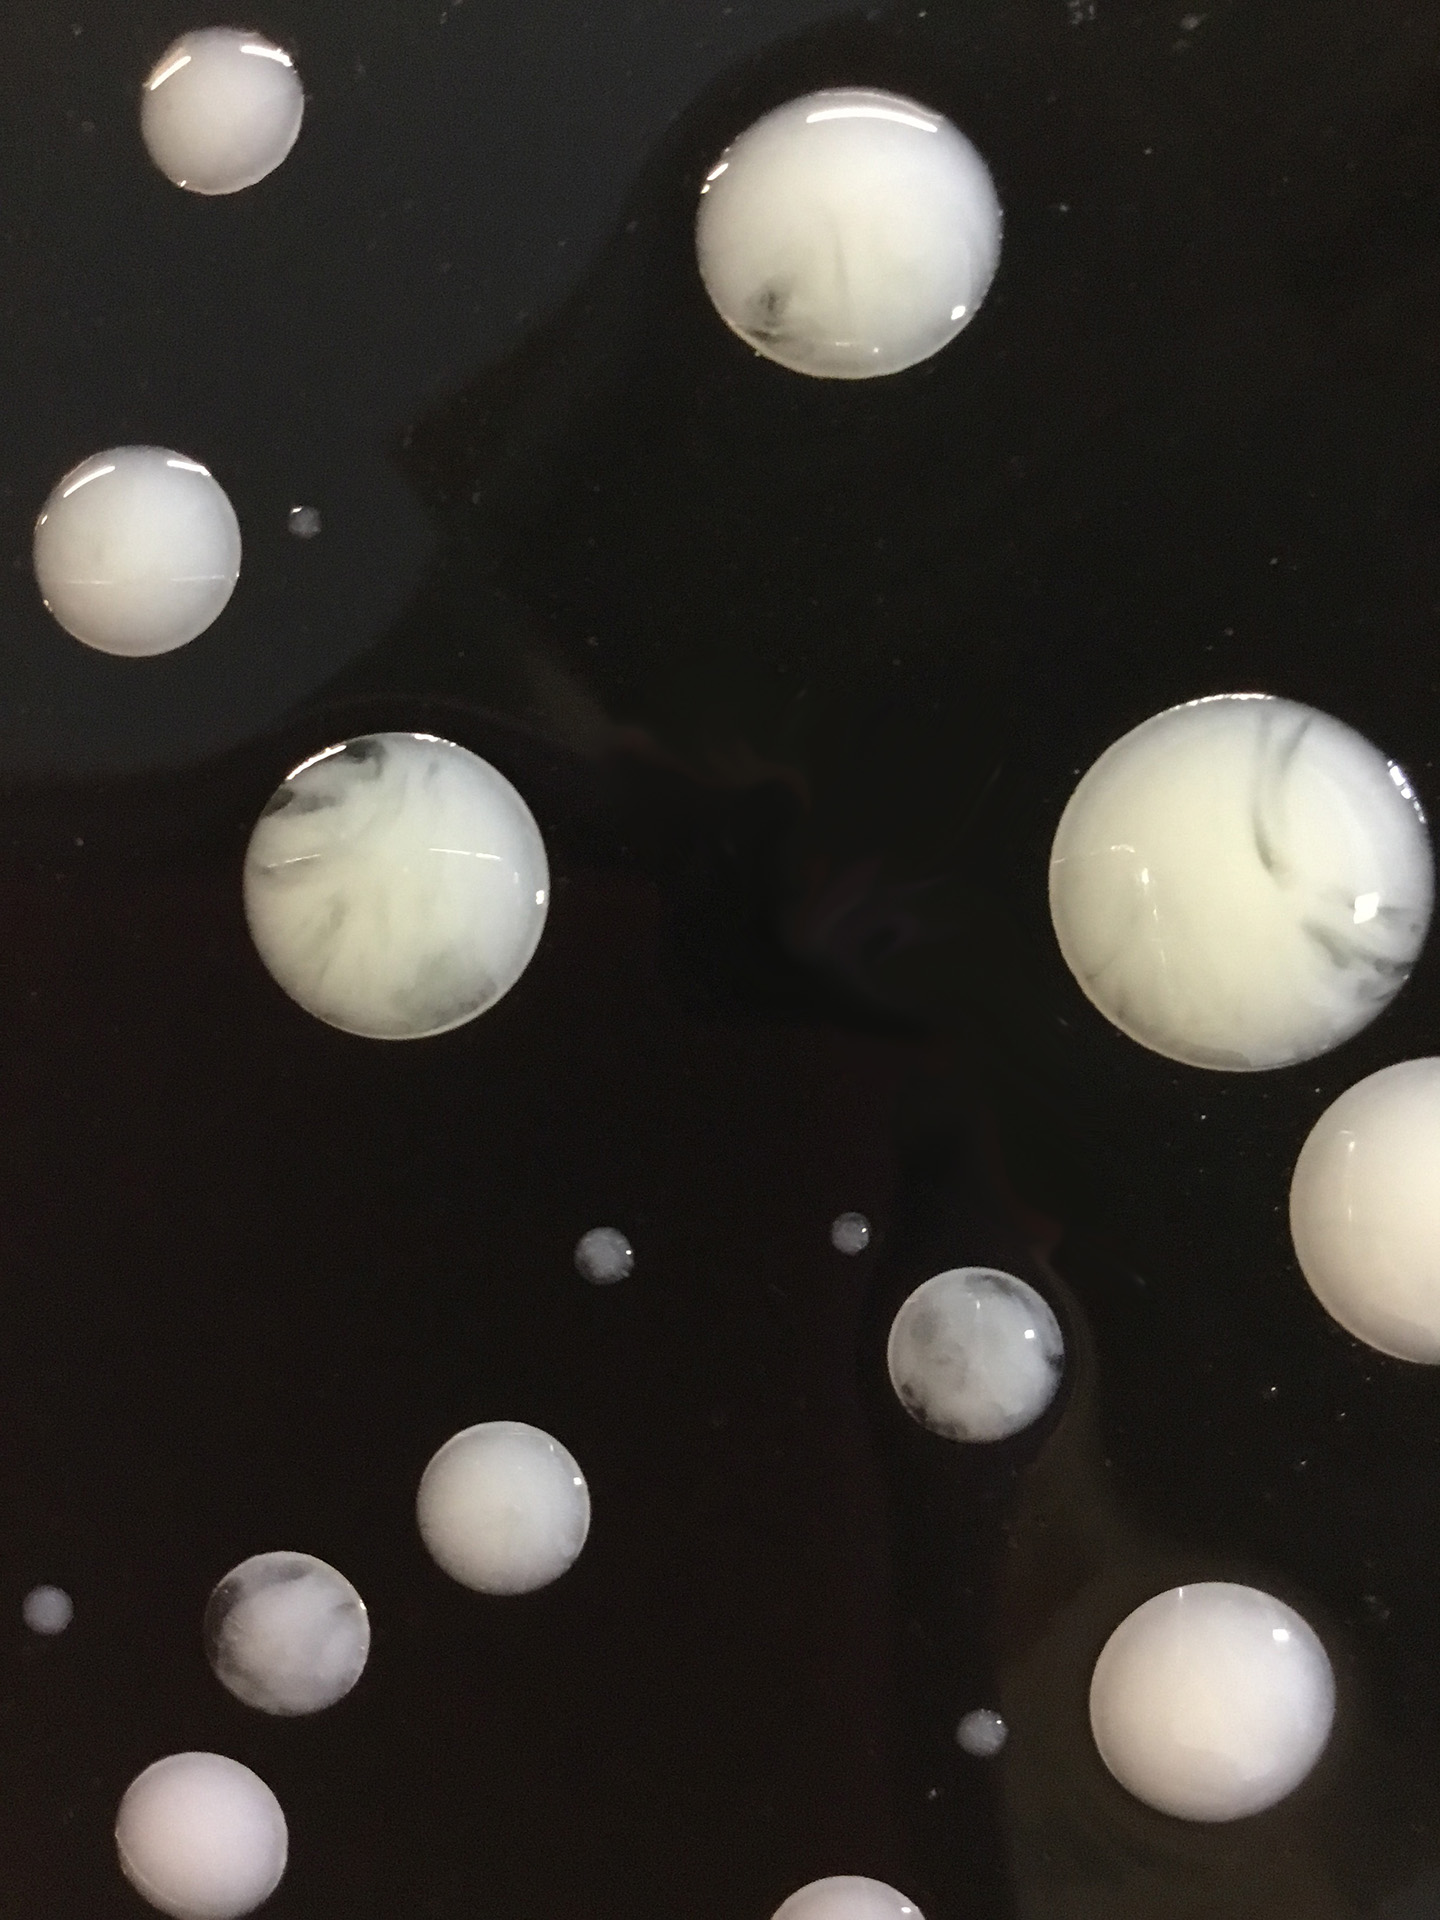

藝術中的科學
物理科和化學科以「水溝油」單元中的藝術作品為基礎,讓學生探究水與油不相溶的科學原理及其應用。
在媒介探索中,運用水與油的物理特質,並估算含有不同成份的水溶液與不同的油,可能出現的視覺/化學現象
在實驗的反思中,除考慮不同視覺效果(例如色彩、質感、構圖)外,亦考慮影響視覺效果的因素(例如物料混合時間、份量、運動速度、環境溫度)

在自評與互評實驗產生的作品時,運用美術詞彙和科學專門術語或概念
總結媒介探索的心得,並就未能解決的疑難向不同領域的老師請教後,開始創作
完成水溝油單元創作後, 對水與油的物理性及化學現象有較深入理解, 並對相關特質在生活上的應用有更敏銳的觀察

學生能通過水和油的不同組合,捕捉偶發效果,運用相關經驗,拍攝水和油的變化

學生結合色彩與油珠的不同效果,改變畫面氣氛

例子一 : Iceberg


例子二 : Tadpole


例子三 : Tiny Universe


學生在回應藝術作品時,能結合審美經驗和科學探究的推論,更具體和清晰地表達觀點學生較願意就同儕的創作提出意見和疑問,亦較積極辯解自己的觀點和意念


照片中用了藍色主調,令人聯想到海洋世界,水底下看到一群魚兒在自由地游動,魚兒們好似吐出一串串氣泡,令畫面充滿生命力

黃色和紅色的液體灑滴於玻璃瓶中,於透明油柱內形成了一道橙紅色的牆壁,當這道牆壁被不斷增加的液體衝破時,紅黃液體便慢慢地向下滲透,形成了一道橙黃色的奪目水龍捲
藍月天上掛,一抹冷月畫
夜中雪降風不息,殘風飄絮雪打萍,
黑暗中雪逐沉蝕,誰能參悟世浮沉。